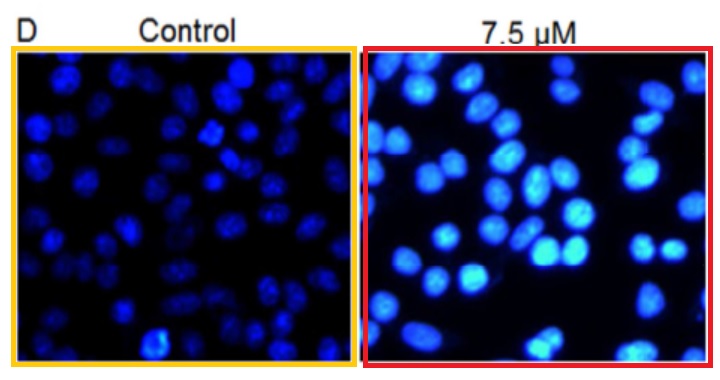

Smut Clyde is a crime detective who solves the most tangled science fraud cases and makes every fake figure confess at the end. For some time now, he has been exposing paper mills, highly popular service providers in China which generate fake scientific papers for their paying customers in hospitals and academia. The papermillers even handle submissions to journals and apparently also handle corrections when caught and answer on PubPeer.
Now Detective Smut Clyde uncovered an even crazier case. A small, insignificant, yet PubMed-whitelisted Balkan journal became victim of a Chinese paper mill. Its editor announced a tough crackdown on fraud. So far so unsurprising. Yet behind the scenes, same journal editor and his colleagues have been stealthily replacing fabricated figures, sometimes as fast as 3 days from initial PubPeer posting to pdf replacement, all without any trace. Well, Smut Clyde found traces.
The Journal of the Balkan Union of Oncology (J BUON) are cheapskates with an appallingly dysfunctional website who don’t even provide DOI numbers to the papers they publish. Yet it is also rather cheap, merely €470 a pop. J BUOn is PubMed listed and run by Balkan academics from Greece, Serbia, Turkey and Bulgaria, the editorial board features names from the wider world, including USA and western Europe.
The authors are almost all Chinese biomedical “scientists” who bought a fake cancer research paper from a paper mill. Some even reply on PubPeer, or maybe it is their papermill service providers who reply. Some announce retractions that will never happen, one of the authors even pretended to be dying of terminal cancer (he lied).
The journal editor lies also. On 6 January, Chief Editor Nasis Athanasiou, director of Metaxa Cancer Hospital in Piraeus, wrote in an email to a pseudonymous paper mill investigator:
Dear dr. Muller,
Thank you for your recent informative email. We read very carefully your observations and we agree with them. Quite recently we discovered that we were victims of a number of Chinese authors who submitted their falsified articles to our journal. Other people (pubpeer) have also informed us about this situation. We now use advanced programs to locate and reject such articles.Best wishes and happier new year,
Nasis Athanasiou
After which Athanasiou went back to serving his paper mill customers by stealthily correcting fraudulent papers. Almost 60 such papers were “fixed” in December 2020-January 2021, and the editors are just starting. In one case, ALL figures were secretly replaced.
If you think this practice of stealth corrections never happens in “proper” journals: no. Oxford professor Kay Davies, Dame Commander of the Order of the British Empire, runs a tight ship on her Human Molecular Genetics journal. Fraud evidence (even in own papers!) is buried, stealth corrections are issued and whistleblowers get reported. J BUON editor just learned from the best!
Smut Clyde attributed over 260 fabricated papers to that new Chinese papermill, most fictional papers were published in J BUON, but also with other PubMed-listed scholarly outlets. As usual in such cases, Smut Clyde’s investigation was assisted by Tiger BB8.
The Google-Sheets file is available here.
For visitors from China without access to Google services, here a pdf:

Ambrosin, Baicalein, chrysoeriol, davanone, Eriodictyol, flavokawain-B, Geraniol, helenalin, Imperatorin, Juglone, Kaempferol, Lycopsamine, α-mangostin, Murrayanine, Norwogonin, Oridonin, Pleuromutilin, Royleanone, Sugiol, Tangeretin, Ursolic acid, Voacangine, Wogonin, Xanthohumol and Zingiberene
By Smut Clyde
Please admire these single-use burner Yahoo identities, used once each for submitting a manuscript to the Journal of the Balkan Union of Oncology (J. BUOn), then consigned to the realms of darkness and silence as soon as it was accepted. The list evokes a sense of mortality and the tragic brevity of existence. Their creators have confidence in their capacity to span an endless succession of delightful personae, and “DanyelSsche” is the only one I have seen recycled to submit a second manuscript.
TBarnebesaull@yahoo.com sporusac@yahoo.com RichieWattsfdv@yahoo.com BrattinOdod@yahoo.com RLakeshiattebe@yahoo.com StaciNcrod@yahoo.com MMadalynywa@yahoo.com AlistadLhos@yahoo.com DCassienne@yahoo.com KNanceylse@yahoo.com DanyelSsche@yahoo.com RBellengob@yahoo.com
One might expect the editors to wonder why Yi Xiao (for instance) opted to communicate with them through the mouthpiece of “EmileJohnstongln@yahoo.com” — especially when the same author had used a more convincingly institutional e-address for two other papers, immediately before and after in the journal’s pagination. On the other hand, more situationally-aware editors would have noticed the same Figures turning up again and again in manuscripts purportedly contributed by otherwise-unrelated research teams (to say nothing of the journal’s peer-review corps who were equally oblivious to the repetitions). On the prehensile tail, nor were editorial suspicions aroused by the tsunami of authors asking Santa Claus for “Urgent changes to their publications” for Xmas (replacing one or more bogus Figures with something less obviously fake).
The editors spent the festive season dashing around behind the scenes like one-armed puppeteers, tasked with making Stealth Revisions. For a series of J. BUOn papers had inspired Indigofera Tanganyikensis and Elisabeth Bik and Tabebuia Rosea to comment upon their problematic Figures, at the PubPeer platform for post-publication peer-review. It looks like people read PubPeer (which will be gratifying for the site’s founders)… Ninja Corrigenda followed, and so much has been swept under the carpet in the J. BUOn editorial office that it must now resemble a scale model of the Himalayas.

There is nothing in the journal’s Tables of Contents to announce that the versions of the papers currently hosted there differ from the versions originally published (and indexed in PubMed), and the only clue is the recency of the Created / Modified field in the PDF metadata. Most of these reconstruction projects had been archived at ResearchGate on behalf of the putative authors, allowing a comparison between iterations and documenting the closeness of the collaboration between the journal editors and their imaginative contributors. As it happens, the editors are already called back behind the scenes for a second round of evidence-erasure, as falsifications come to light that the first round overlooked, or because the hastily-prepared replacement Figures are if anything more bogus than the fakes they replaced. I’ll come back to that.
Right now, welcome to the first papermill of 2021!
Yes, there is an on-line spreadsheet.
I propose to approach the topic indirectly, circuitously (as is the custom of my people). A second introductory theme is ‘hipster ethnopharmacology’. We have already met the first related theme: Yahoo e-addresses and their tragic ephemerality. These provide a useful clue to provenance, by the way: a paper might be papermill-sourced even if the corresponding e-address is plausibly related to the nominal author’s name, but if the address is (say) “JereCummingsjux@yahoo.com”, then the real author is seeking financial compensation rather than recognition.
The academic speciality of ethopharmacology is flourishing, if the multitude of journals serving it are any guide. If a plant has any place in any folk pharmacopoeia, sooner or later it will take its turn under the microscope (or more accurately, inside the chromatograph), with eager researchers isolating and characterising its active ingredients. Or failing that, isolating any secondary metabolites distinguishing it from other plants. For evolution, and the advantage that comes in the evolutionary race from not being eaten, has taught plants to deter potential consumers by packing their leaves and fruit and roots with molecules that are sand in the metabolic machinery of herbivorous mammals (and birds, insects, molluscs). The corollary follows (as corollaries are wont to do) that these secondary metabolites must have some therapeutic applications. It remain, then, to test each molecule in vitro or in animal models of all possible medical conditions (since folk-medicine indicative categories like “excess black bile” or “imbalance of qi energy” are not as helpful as one might think).
Oncological candidates are especially helpful, for it goes without saying that phytochemicals designed to deter animal consumption will also cripple the previously-unchecked proliferation of cancer cells. The industry has not yet exhausted all combinations of “phytochemical X” and “vat-grown cancer cell-line Y”. Perhaps the papermills can help!

Here “X” comes from a chemical cavalcade including Ambrosin, Baicalein, chrysoeriol, davanone, Eriodictyol, flavokawain-B, Geraniol, helenalin, Imperatorin, Juglone, Kaempferol, Lycopsamine, α-mangostin, Murrayanine, Norwogonin, Oridonin, Pleuromutilin, Royleanone, Sugiol, Tangeretin, Ursolic acid, Voacangine, Wogonin, Xanthohumol and Zingiberene. These are variously classified as chalcones, diterpenes, deterpenoids, flavones, flavonoids, sesquiterpene lactones, terpenoids etc., for it is not enough just to be an ‘alkaloid’ these days. Coca-coline and Yoyodeine are not on the list, as researchers collectively lacked the commercial nous to sell naming rights for this molecular abecedarium.


If you are like me, you want to know which secondary metabolites are popular and which are passé, and which ones to learn about now so you can boast that you were studying them before they sold out and went mass-market. No-one wants to be in the position of a mystery novelist whose characters are still poisoning with strychnine when all the hip authors have moved on to ricin. It turns out that there is a special place in the cavalcade for Daidzein, with one specific paper accruing 71 citations:

Some of them are systematic reviews, or an inclusion in some Introductory Context section padded out with vaguely relevant stuff where an author had time for a G**gle Search but not enough time to read the hits. But there are so far 50 papers in my spreadsheet citing Hua et al (2018). Sometimes to exemplify concepts and methods which Hua et al never mentioned — the quantification of RNA with PCR; or ROS and mitochondrial membrane potential levels. They did mention cell-cycle arrest and quantifying apoptosis with flow-cytometry, but hardly as pioneers, so it is remarkable that so many authors independently chose to use them as the reference description. In a standardised way. Often involving covers-lips.

It’s conceivable that a computer virus inserted itself into 50 authors’ word-processing software and copy-pasted certain paragraphs into whatever manuscripts were half-written at the time. We should also consider the alternative explanation, that a papermill is churning out the product by sticking to templates, changing the phrases just enough to avoid triggering automated plagiarism detectors.
It is hard to choose where to begin with this sprawling continuum, where shared graphic elements link any paper to many other papers. Western-Blot bands change protein ID and lane conditions to turn up in another WB. Flow-cytometry histograms are modular; the peaks can be taken apart and reassembled in new arrangements to demonstrate entirely different claims. Flow-cytometry scatter-plots gain or lose points. Fluorescent-stained panoramas of cell cultures, color-coded by their post-treatment viability, yield enlarged details to illustrate different cell-lines and different treatments.



It is a kaleidoscopic phantasmagoria, and I need to be reminded that “however entrancing it is to wander unchecked through a garden of bright images, are we not enticing your mind from another subject of almost equal importance?” To remove this paralyzing excess of choices, I will pick the next few cherries from the narrow focus of the 50 papers of the Daidzein corpus.





The Daidzein subgenre also reminds us that these molecule / cancer-type / cell-signaling-pathway MadLibs do get cited (with the usual caveat that citations do not imply a readership, when it is enough for a title and abstract to show up in authors’ searches for corroborative detail to lend verisimilitude to their otherwise bald and unconvincing narratives). The 71 citations for Hua et al. are an outlier, riding on the coat-tails of a template, but “Baicalein induces apoptosis in esophageal squamous cell carcinoma cells through modulation of the PI3K/Akt pathway“, “Anticancer and apoptotic activities of oleanolic acid are mediated through cell cycle arrest and disruption of mitochondrial membrane potential in HepG2 human hepatocellular carcinoma cells” and “Genistein induced anticancer effects on pancreatic cancer cell lines involves mitochondrial apoptosis, G 0 /G 1 cell cycle arrest and regulation of STAT3 signalling pathway” (respectively accruing 67, 56 and 39 citations) hit the same sweet-spot of clickbait citability.
That said, J.BUOn is hardly a high-impact-factor outlet (Impact Factor = 1.695). If the present papermillers confined themselves to its pages, they would lose their already-limited interest to readers. However, they are naturally ambitious to extend further afield. We find more of the implausible Yahoo identities in Medical Science Monitor (33 papers in the spreadsheet), and in Archives of Medical Science (17 papers). I know nothing of these journals except that they’re not dominated by papermill persiflage… it may be that a systematic search would reveal many more Easter Eggs. AMS is from a Polish publisher and has a slow-moving pipeline, in which a paper that was accepted in 2017 might be delayed until there is space for it in a 2019 issue, so its pages are time-capsules of the papermill’s stylistic evolution from a few years earlier. Also 15 papers spread across various Elsevier journals (notably Archives of Biochemistry and Biophysics and Biochimie); five in AMB Express, from Springer; and six in the egregious European Review for Medical and Pharmacological Sciences.
I must not overlook the 18 productions which found their way into journals from Spandidos Publications (Oncology Reports, Oncology Letters and Molecular Medicine Reports), or the nine into journals from e-Century (International Journal of Clinical and Experimental Pathology and American Journal of Translational Research). There are undoubtedly more. In fact the dates suggest that the scriveners began their depredations there, with J.BUOn as only a secondary host. ‘E-Century’ is located several sub-barrels below the bottom of the barrel, but is still subsidised by the US government which archives their contents and lists them in PubMed. IJCEP and AJTR are ‘International’ and ‘American’ in the sense that the proprietor does indeed reside in Wisconsin, thereby fulfilling the requirement levied on Chinese authors that they publish in a non-China journal.
As for the Spandidos press, a fall-from-grace narrative is waiting to be told there. The eponymous founder Demetrios Spandidos was widely seen as a contender for a Nobel Prize until someone asked to see the receipts for all the laboratory rodents on which he conducted his purported experiments… everything went tits-up and he turned to predatory publishing instead. Episodes of that tale are scattered across footnotes to other people’s stories and this is not the place to bring them all together. [Demetrios Spandidos happens to be editorial board member of J BUOn though, – LS]
In those early manifestations, the Photoshopping was clumsy and the contempt for the audience was poorly-concealed. The results were homages… to Monet waterlilies (h/t Elisabeth Bik), or to the classic Space Invaders arcade game, with serried ranks of cell-cluster sprites.




I hasten to add that appearance in J.BUOn is not definitive proof that a faked paper came from our current papermill. The attribution of some entries in my spreadsheet could be false. It is not as if our subjects held territorial rights over J.BUOn to stop other fantasists from using its services as well (one entry seems to be from the ‘Contractor’ papermill). Nor is there anything, other than stringent peer-review, to stop authors of genuine papers from making innocent mistakes like using the same Figure twice (not overlapping with other papers with different authorship). Even with that caveat, though, there are at least 250 of these mock-science fantasies (and the end is nowhere in sight), collecting citations and competing with real cancer-research findings.
The Yahoo email instantiations are dispositive, but not universally present. Their use did not become standard until 2018, so the attribution of earlier papers is more speculative. There is stylistic continuity and recycled images although the Space-Invader compositions are more skillful in later examples.

It is anyone’s guess whether the papermillers have a research day-job, and came by their own Figures, or just found them elsewhere in the literature, insufficiently fastened down. In one case they appropriated Western Blots that are clearly fakes from the ‘tadpole’ mill, which aroused Indigofera’s suspicions and set off this whole line of inquiry.

Our anonymous scriveners are most comfortable composing fairy-tales about apoptosis pathways to cancer-cell destruction — to be more accurate, about autophagy pathways. Of course this does not narrow the scope enough to dox them. Autophageosomes — one of the Four Horsemen of the Apoptocalpyse — occupy a central place in their enhanced and recycled Transmission Electron Microphotographs.


The Apoptocalypse Horsemen include fluorescent stains, lighting up cells blue or green or yellow or red according to their viability or stage of self-destruction.

To be fair, the scriveners are willing to step outside their comfort zones, and on reasonable request they turn their talent for bricolage to the micro-RNA genre of fiction instead.
Now I am not saying that J.BUOn is a knowingly predatory journal, in Jeffrey Beall’s sense. I am confident that when oncologists in the Balkans decided to unionise and to found a scholarly organ, they had benign ambitions and no long-term intention of creating a conduit by which papermills could disguise their MadLibs-composed cancer-cure CV-stuffers behind a veneer of academic approval. This is probably something they drifted into, as the journal was hollowed out by the Invisible Hand of the Market wielding an equally-invisible melon scoop. Along the way they collected a corps of reliably-complaisant peer reviewers, all members of the Totem of the Rubber Stamp, though they may or may not be more sock-puppets. And now J.BUOn rings the changes on the phytochemical novelties, pairing each one with different cell-lines of domesticated carcinoma (always with promising results to report, warranting further study).
The PubPeer back-end automagically sends authors invitations to join the discussions, and some have replied. Some ascribe the recycling or manipulation of images to poorly-mentored students, and promise retractions to come.
Dear professor, thanks for your comments, with obvious deficiency , we had withdraw the manuscript. Thanks for all your concern and efforts.
#2Deer Tanganyikensis and Camphorifolia We deeply respect your comments and advice, and we have carefully investigated our raw data immediately. It turned out that there were indeed errors in these images. We would like to apologize to you, and show our thanks to you for pointing out our errors. We admire your serious and rigorous attitude towards scientific research. In fact, most of the experimental results in our research group were provided by students who conduct the corresponding experiments. Our experimental results are reliable. But this time, after our investigation, we found that the managers of the lab did not carefully check the Figures in this article, resulting in repeated images in the Figures. We We don’t allow flawed articles to be published. We are now connecting to the journal to withdraw the artical,and promises it will never happen again. We will update you the information later. Many thanks again.
I am responsible for this project and the manuscript, and I will be responsible for all subsequent problems associated with this study. Thank you very much for your serious works and pointing this questions. Currently, I am in the process of contacting the editorial office for further discussions regarding withdrawal and correction of this manuscript. Sincerely yours, xiaobin Li
Thanks for pointing it out. We will check the data and repeat our experiment. In order to assure the scientificity,we have contacted the editor to withdraw the article .
Alas, although the editors can create and upload a new version of a paper within three days of PubPeer comments about the evidence of papermilling, authors’ requests for withdrawal go unheeded for weeks and months. Their correction requests are equally delayed. It’s as if the revisions are coming from inside the house!
We agree with you.
We had already detected this problem. The error was unintentional and we have approached the editor for the correction of the figure 15 days ago. The process is underway.
Some (notably Fa Hua, Qing-Gang Meng and ShuLi Yang) blamed piracy by rival authors. They have my sympathy; many researchers have neither qualm nor scruple, while many journals — even the ones with the PubMed imprimatur — are wretched hives of scum and villainy (we should note that the minutiae of publication dates are such that some of the plagiarism must have occurred even before the manuscripts were submitted).
It is quite obvious that the blots might have been copied from our manuscript published in 2017 in European review for medical and pharmacological sciences.
Anyway, thanks for taking note of it.
We appreciate the notice regarding the overlaps of Figure 5B in our published article entitled with”MicroRNA-1179 inhibits the proliferation, migration and invasion of human pancreatic cancer cells by targeting E2F5” on Chem Biol Interact on 2018 May 31st with Figure 8 in the published article (PMID: 30879017) on Med Sci Monit. by Zhang JB et al on 2019 Mar 17th. We have carefully checked these issues, and we astonishingly find that the photos of Figure 8 in Zhang’s article look like just small parts of the photos of Figure 5B in our article. We don’t know how this could happen.
The manuscript entitled MicroRNA-34 suppresses proliferation of human ovarian cancer cells by triggering autophagy and apoptosis and inhibits cell invasion by targeting Notch 1 is our original research work. It took a little time to respond since we ourselves were shocked with the mysterious similarities of our manuscript with the paper entitled ‘MicroRNA-29 targets FGF2 and inhibits the proliferation, migration and invasion of nasopharyngeal carcinoma cells via PI3K/AKT signaling pathway’ published by European review for medical and pharmacological sciences
Nonetheless, after examining the manuscript, we found the authors have copied significant portion from our manuscript. This is clear from the legends of Figure 1. You can see the authors used WST assay to examine the cell proliferation in the methodology part, but in the legend of Figure 1C, they mention CCK8 assay was used to examine cell proliferation. This is because they copied it from our original manuscript and forgot to edit it (Note that we used CCK8 assay in our manuscript). This could explain why the paper was later retracted by the Journal

Zhang et al (2018) was pre-emptively pillaged repeatedly. By (at right) Shi et al (2019)…

By Pan & Zhang (2019) (at left) and Luo et al (2019) (at right)…


By Pan & Zhang again, and by Wu et al (2018), and by Chen et al (2019)…

Dear Hoya,
I don’t know who you are but you are doing it nicely. I have been diagnosed with advanced stage malignancy and do not check my emails regularly. Just before I was about to go far a walk, I checked my email and found one notification from Pubpeer. Consistently, I decided to reply with just one sentence. I can’t do anything more at this stage of my life.
The manuscript entitled ‘The Effects of Ludartin on Cell Proliferation, Cell Migration, Cell Cycle Arrest and Apoptosis Are Associated with Upregulation of p21WAF1 in Saos-2 Osteosarcoma Cells In Vitro’ published in Medical science Monitor in 2017-18 is our original work and all those articles that show similarity to our article have been published after our article.
It is OK, that you are pointing out the similarities between the articles but many a times an original article is also dragged into the thread. While it may not matter to others, it is quite an embarrassment for me (and many others) at this stage of my life.
Take care Wish you health and happiness
We learn elsewhere that Meng fell out of favour, “suspected of serious violations of discipline and law, and is currently undergoing disciplinary review and supervision and investigation“. G**gle Translate charmingly renders the Chinese headline as “Meng Qinggang, the former president of Harbin First Hospital, had an accident“, but I suspect that “something unfortunate happened to him” might be more accurate [h/t TigerBB8].
Fa Hua is nominally the author of that seminal, citable work on Daidzein.
Our manuscript was published in 2018 and the study was performed long time ago. The article was submitted to different journals and ultimately ended up in International Journal of Molecular Medicine. I have moved to a different country in different institute since then
Afterwards, if somebody copies our article wholly or in part, We surely are not responsible.
So there are repeat customers, who came back for a second serving… a tribute to the high quality of the papermill’s products, or their bargain price. ShuLi Yang is in the list six times. Yi Xiao, thrice. A group from Fudan University Shanghai Cancer Center around Yiqun Du have published six times (thrice as DanyelSsche). One paper has been retracted, for they are not fooling around at Medical Science Monitor, while the fate of two others depends on editorial caprice at Archives of Medical Science and AMB Express, but J.BUOn editors have accepted amendments for the other three.
Coming back to the clandestine corrections, Wei et al (2019) and then Lu et al (2019) needed a double dose, because suspicion fell upon figures left unchanged in the first round. This is what happens when patches are prepared in haste. Other patches had their own dumbprints of fabrication and will need remediation of their own.


In some recent corrigenda, the editors replaced all the original figures, which I take as a tacit admission that the scriveners couldn’t remember which ones (if any) were legitimate. If only there were a way that journal editors could signal to readers that the results originally presented in a paper were all fictitious… we could call it (just spit-balling here) “Retraction”.
Since the papermiller generated e-addresses for “corresponding author”, presumably they also handle the correspondence, including the invitations from PubPeer. It may be that requests for revisions of J.BUOn material generally come from them. In the absence of acknowledgement of the corrections, let alone explanations, we can only speculate.

I am advised by people who contacted the J.BUOn office that the editors present themselves as the real victims here. Nefarious papermillers exploited the journal, taking advantage of loopholes in the system for peer-review, but these have been closed to prevent any recurrence. The credibility of this claim of victim status was undermined by the subsequent stealth amendments, working to improve the plausibility of the impostures rather than retracting them. It is almost as if the editors’ real priority is to reward the papermill as a loyal customer.
Literature scholars have the useful term ‘ekphrasis’, meaning ‘a detailed, admiring description of an artwork imagined by the author’. The ultimate exercise in ekphrastics is the Hyperotomachia Poliphili, 400 pages of ecstatic reveries over one imagined sculpture or monument after another. Encountering the phenomenon of papermills opened my eyes to the possibility that ekphrasis could also come to dominate science, with a huge literature of descriptions of experiments so beautiful that they should have happened (though they didn’t).
I leave you with some final examples of the editorial repairs.




Donate to Smut Clyde!
If you liked Smut Clyde’s work, you can leave here a small tip of 10 NZD (USD 7). Or several of small tips, just increase the amount as you like (2x=NZD 20; 5x=NZD 50). Your donation will go straight to Smut Clyde’s beer fund.
NZ$10.00

European Science Editing (ESE) is another example of a peer-reviewed journal which offers the service of stealth corrections. This Scopus-indexed journal is owned by the European Association of Science Editors (EASE).
Ksenija Baždarić is the EiC of ESE. Baždarić is since 2012 Research Integrity Editor at the Croatian Medical Journal. Source: http://www.cmj.hr/default.aspx?id=28
The stealth correction refers to https://ese.arphahub.com/article/52201/ (“Dealing with difficult authors”) and is documented at https://web.archive.org/web/*/https://ese.arphahub.com/article/52201/
EiC Ksenija Baždarić is listed as Academic Editor for this article. She was contacted for the first on 10 July 2020 about issues with this article. Only 2 auto-replies have been received until now.
The peer-reviewed article “Dealing with difficult authors” was written by Pippa Smart. This article was published on 29 April 2020. Pippa Smart was at that time chair of the board of EASE. There are thus motives to argue that EiC Baždarić can be regarded as some sort of subordinate of Pippa Smart.
The stealth correction refers to the removal of the sentence “The author has declared that no competing interests exist.” This stealth correction took place at or shortly before 29 July 2020. Much later, a correction was published in which new affiliations were added and in which added details about conflicts of interest of Pippa Smart were added. Pippa Smart is at the moment Director al-large of WAME. Source: https://www.wame.org/wame-executive-board-and-committees
It is not excluded that people might wonder why Pippa Smart has submitted the manuscript “Dealing with difficult authors” to a peer-reviewed journal of which she was at that time chair of the board of the owner of this journal.
LikeLike
Wow. Smut looks like he should be in ZZ-top plating along side Billy Gibbons: A-haw haw haw-haw
Heh,a-haw haw haw
LikeLike
Hilarity continues at J.BUOn where the editors have quietly revised over 80 papers. The editors are aware that fabrications from papermills occupy many of the journal’s pages. They’re aware that the figures are copy-pasted, or Photoshopped, or both. So they’re swapping in new figures to make the papers look less fraudy.
The shortest time so far between a critical comment at PubPeer and a stealth correction of the offending Figures is one day:
https://pubpeer.com/publications/5A8F97D8A56CAA0714C5BF573F4E29
https://pubpeer.com/publications/84EAE1029A59A777FBBB84A90DABE8#
I don’t really believe that an outside company could have sourced new, less-fake images and forwarded them to the journal in time for this swift replacement, leaving us with the option that the Editors are also running the papermill.
LikeLike
“[L]eaving us with the option that the Editors are also running the papermill.” Or, alternatively, that the papermill is running the Editors.
“The creatures outside looked from pig to man, and from man to pig, and from pig to man again; but already it was impossible to say which was which.”
LikeLiked by 1 person
Stealth corrections are towards my opinion very difficult to study.
Anyone aware if there are publications in peer-reviewed journals about this phenomenon?
Publisher Taylor & Francis is also offering this service for the journal ‘Zoology in the Middle East’, https://www.tandfonline.com/toc/tzme20/current
A clear case is documented at https://osf.io/cvu5b/ The case refers to adding a sencence (“We note these allegations were not made by any of the authors of the “Comment” and the “Rejoinder”) to an Expression of Concern. This Expression of Concern does not list an author. TF was contacted about this issue in the beginning of August 2016. A short response was received within a few hours. There is until today no follow-up. It seems likely that Max Kasparek, the Editor-in-Chief of this journal, is (one of the) author(s) of this Expression of Concern. Max Kasparek does not communicate with me since the beginning of May 2015.
It seems to me that it is worthwhile to see if it’s possible to get more insight in this phenomenon.
LikeLike
Pingback: Towards equal opportunity for prostate, breast and ovarian cancers – For Better Science
The most recent J.BUOn issue includes five Retractions and five Expressions of Concern, with the recurring theme: “Following the publication of the above article, readers drew to our attention that part of the data was unreliable. The authors were requested to provide the raw data to prove the originality, but were unable to do so.”
https://jbuon.com/26-1/
The editor’s notes don’t mention earlier stealth corrections to the papers.
LikeLike
Pingback: The Chinese Paper Mill Industry: Interview with Smut Clyde and Tiger BB8 – For Better Science
Retractions continue apace at J. BUOn! Seven retractions in the July / August 2021 issue, and 10 Expressions of Concern in the May / June issue.
The repeated refrain continues: “We sent emails to the authors with a request to provide the raw data to prove the originality, but received no reply”. This is curious, as the retracted or concerning papers had undergone a stealth correction to replace a fabricated image with something less obviously faked… or two corrections… or in the case of Zhu et al (2020), three stealth amendments in response to Pubpeer critiques of earlier revisions. So who was providing the replacement images, if the authors were not communicating??
In all cases, the papers were reverted to the original versions before their retraction or Expression of Concern, in a pretense that those revisions never happened.
Oridonin: https://pubpeer.com/publications/7904D7C12E174F03737846B5451AC6
Dammarenediol: https://pubpeer.com/publications/771875DF895156FDB92E8650F178E9
MicroRNA-23: https://pubpeer.com/publications/136066E0869A9722DAF0424D0D179A
HHIP gene: https://pubpeer.com/publications/84EAE1029A59A777FBBB84A90DABE8
Lycopsamine: https://pubpeer.com/publications/E8553755431BEAE89E437DE3816A28
Acetylshikonin: https://pubpeer.com/publications/26D9696913A57A05921C4959A01860
Ovatodiolide: https://pubpeer.com/publications/38C57C5E38B7A8A29A48C495B5B6A3
LikeLike
Pingback: Cyclotron Branch, Before the Fall – For Better Science
Pingback: The papermills of my mind – For Better Science